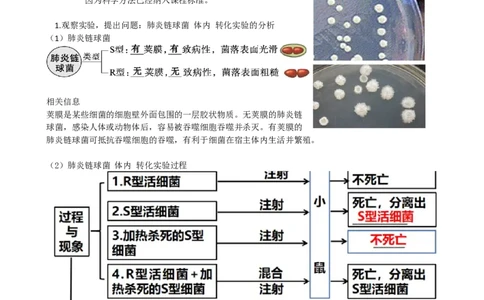
第20讲DNA是主要的遗传物质（讲义）（学生版）_2024年新高考资料_1.2024一轮复习_2024年高考生物一轮复习讲练测（新教材新高考）

文档内容
第20讲 DNA是主要的遗传物质
1.总结“DNA是主要的遗传物质”的探索过程;领悟科学研究的过程和方法,培养学生的实验探究能力。
2.分析证明DNA是主要的遗传物质的实验设计思路;探讨实验技术在证明DNA是主要遗传物质中的作用。
3.理解DNA是主要的遗传物质。
考点要求 考题统计 考情分析
肺炎链球菌的体内转 2021,全国,选择
化实验 本专题知识难度较低、基础性强。考查学生对
细胞整体性的认识,或结合一些情景信息或表格
肺炎链球菌的体外转 2023,天津,选择
信息设置题目,考查学生的应变能力、获取信
化实验
息和综合分析能力。
噬菌体侵染细菌的实 2022,海南、浙江,选择
验 2021,浙江,选择
生物的遗传物质考点一 人类对遗传物质的探索过程
感悟:现代科学研究中常用的一种科学方法——假说-演绎法
在观察和分析基础上提出问题以后,通过推理和想像提出解释问题的假说,根据假说进行演绎
推理,再通过实验检验演绎推理的结论。如果实验结果与预期结论相符,就证明假说是正确的,反之,
则说明假说是错误的。
因为科学方法已经纳入课程标准。
1.观察实验,提出问题:肺炎链球菌 体内 转化实验的分析
(1)肺炎链球菌
相关信息
荚膜是某些细菌的细胞壁外面包围的一层胶状物质。无荚膜的肺炎链
球菌,感染人体或动物体后,容易被吞噬细胞吞噬并杀灭。有荚膜的
肺炎链球菌可抵抗吞噬细胞的吞噬,有利于细菌在宿主体内生活并繁殖。
(2)肺炎链球菌 体内 转化实验过程
对此实验,不同的科学家分别做出三种质疑:
①R型菌以某种方式使加热杀死的S型菌“复活”。②S品系死菌刺激小鼠体内产生免疫物质,后者刺激R品系突变成了S品系。
③S型菌的遗传物质进入R型菌,合成了S型菌的荚膜。
1931年,道森和西亚成功地在体外进行了转化实验:只在培养皿中使R型菌转化成S型菌,不需要以小鼠
为媒介。——这否认了因小鼠体内免疫物质诱导的解释。
1933年,阿洛维将R型菌和S型菌的无细胞提取液(所有完整细胞、细胞碎片、荚膜分子都通过离心和
过滤从提取物中去掉)混合,培养皿上仍长出了 S型菌。——这否认了R型菌以某种方式使加热杀死的S
型菌“复活”。
结论是S型菌细胞提取物中含有转化因子,而它的化学本质还是未知的。
(3)提出问题:转化因子是什么?
蛋白质不能作为遗传物质的证据:
①蛋白质不能进行自我复制
②蛋白质在染色体中的含量往往是不固定的,分子结构也不稳定
③蛋白质不能遗传给后代
2.根据事实,提出假说:肺炎链球菌 体外 转化实验的分析
(1)实验思路:
设法逐步去除S型细菌的各组分后分别与R型活细菌混合培养,观察是否具有转化活性。
(2)实验过程:
结论:DNA才是使R型细菌产生稳定遗传变化的物质;
①艾弗里的体外转化实验既证明了DNA是遗传物质,同时证明了蛋白质等不是遗传物质;
②被转化的R型菌只是少量,在培养后既有R型细菌又有S型细菌的培养基中,R型菌的菌落占多数;
③蛋白质和核酸对于高温的耐受力是不同的。在80-100 ℃的温度范围内,蛋白质失活,DNA双链解开;
当温度恢复至室温后,DNA双链能够重新恢复,但蛋白质的活性无法恢复。④该实验的设计遵循哪些原理?其巧妙之处是什么?
遵循单一变量原则和对照原则。
其巧妙之处在于:运用“减法原理”,即在每个实验组人为去除某个影响因素后,观察实验结果的变化
如:在艾弗里的肺炎链球菌转化实验中,每个实验组特异性地去除了一种物质,从而鉴定出 DNA是遗传
物质。
科学方法:自变量控制中的“加法原理”和“减法原理”
加法原理:与常态比较,人为增加某种影响因素。如:与常态比较,人为增加某种影响因素。
(3)提出假说:
实验表明,细胞提取物中含有前文所述的转化因子,而转化因子很可能就是DNA。
艾弗里等人进一步分析了细胞提取物的理化特性,发现这些特性都与 DNA的极为相似,于是艾弗里提出
了不同于当时大多数科学家观点的结论∶DNA才是使R型细菌产生稳定遗传变化的物质。
【教材拾遗】
(必修2 P43“图3-2”延伸思考)体内转化实验中“加热”是否已导致DNA和蛋白质变性?请说明理由。
提示:加热杀死S型细菌的过程中,其蛋白质变性失活,但是其内部的DNA在加热结束后随温度的恢复又逐
渐恢复活性。
(1)格里菲思实验中,第四组死亡小鼠身上分离得到的S型活细菌是由S型死细菌转化而来的。(必修2
P43图3-2)( × )
(2)在艾弗里的实验中,DNA酶将S型细菌的DNA分解为脱氧核苷酸,因此不能使R型细菌发生转化。(必修
2 P44图3-3)( √ )
3.演绎推理:噬菌体侵染细菌的实验
(1)设计(预期)实验及结果
根据艾弗里提出 DNA 是遗传物质的假说,即DNA控制生物的遗传性状
①T2噬菌体的生活方式:活细胞寄生。
②T2噬菌体的增殖
根据艾弗里提出 DNA 是遗传物质的假说,即 DNA 控制生物的遗传性状。
新合成的子代T2噬菌体具有与亲代T2噬菌体相同的遗传特性。
③放射性同位素标记和离心技术。①实验方法:同位素标记,用35S、32P分别标记T2噬菌体的蛋白质和DNA
②实验材料:T2噬菌体和大肠杆菌
③实验过程: A.标记细菌, B.获得标记T2噬菌体
C.侵染细菌(原理图)
特别提醒 搅拌的目的是把吸附在大肠杆菌上的噬菌体外壳和大肠杆菌分开;离心的目的是让上清液中析
出质量较轻的T2噬菌体颗粒,而离心管的沉淀物中留下被感染的大肠杆菌。
D.实验结果分析E.结论:DNA是遗传物质。艾弗里的假说是正确的,艾弗里也证明了DNA是遗传物质。
(3)其他实验及结果--Phi X 174噬菌体实验的分析
后来的Phi X 174噬菌体实验,将病毒分离成DNA和蛋白质衣壳两部分,仅有病毒的DNA就具有感染能力
而病毒的蛋白质衣壳不具备感染能力。这才最终证实了DNA是遗传物质。
艾弗里的假说是正确的,艾弗里也证明了DNA是遗传物质。
【教材拾遗】
教材隐性知识:(1)源于必修2 P46“思考·讨论”:选用细菌或病毒作为探索遗传物质的实验材料的优
点有①②(填序号,下同)。
①个体很小,结构简单,容易看出因遗传物质改变导致的结构和功能的变化 ②繁殖快
(2)源于必修2 P47“练习与应用·拓展应用”:结合肺炎链球菌的转化实验和噬菌体侵染细菌的实验,
分析DNA作为遗传物质所具备的特点是①②③④。
①具有相对的稳定性 ②能够精确地自我复制,使亲代与子代间保持遗传的连续性 ③能够指导蛋白质
合成,控制新陈代谢过程和性状发育 ④在特定条件下产生可遗传的变异
4.总结结论:
DNA是遗传物质,蛋白质不是遗传物质。
(2023·陕西延安高三质检)噬菌体是一类细菌病毒,下列关于噬菌体侵染细菌实验的相关叙述,不正确
的是
A.侵染过程的“合成”阶段,噬菌体DNA作为模板,而原料、ATP、
酶、场所等条件均由细菌提供
B.为确认何种物质注入细菌体内,可用32P、35S分别标记噬菌体的
DNA和蛋白质
C.用35S标记的噬菌体侵染未标记的大肠杆菌,由于保温时间过长所以
上清液中出现少量的放射性
D.若用32P对噬菌体双链DNA标记,再转入未被标记的培养有细菌的
普通培养基中,让其连续复制n次,则含32P的DNA应占子代DNA
总数的1/2n-1
答案:C
解析:为确认何种物质注入细菌体内,可用32P、35S分别标记噬菌体的DNA和蛋白质,即单独研究DNA和蛋白质的作用,B正确;
用35S标记的噬菌体侵染未标记的大肠杆菌,由于35S标记的是噬菌体的蛋白质外壳,其在噬菌体侵染细
菌时没有进入细菌细胞中,且离心后分布在上清液中,保温时间过长会导致子代噬菌体释放,而子代噬
菌体不含35S,因此这不影响上清液中的放射性,C错误;
若用32P对噬菌体双链DNA标记,再转入培养有细菌的普通培养基中让其连续复制n次,根据DNA半保留
复制特点,则含32P的DNA分子数为2个,应占子代DNA总数的1/2n-1,D正确。
【归纳总结】
1.三个经典实验对比
2.S型细菌和R型细菌转化的实质
(1)体内转化实验中“加热”是否已导致DNA和蛋白质变性?
加热杀死的S型细菌,其蛋白质变性失活,DNA在加热过程中,双螺旋解开,氢键断裂,但缓慢冷却时,
其结构可恢复。
(2)资料:R型细菌生长到一定阶段时,就会分泌感受态因子,这种因子会诱导感受态特异蛋白质(如自溶
素)的表达,它的表达使R型细菌具有与DNA结合的活性。加热致死的S型细菌遗留下来的DNA片段会与
感受态的R型活细菌结合,从而进入细胞,并通过同源重组置换的方式整合到 R型细菌的基因组中,使R
型细菌转化为S型细菌。思考:转化为的实质是什么?
转化的实质是S型细菌的DNA片段整合到R型细菌的DNA中,即基因重组。
为什么不是R型菌的基因突变?怎么排除呢?
重复试验1、4组,获得相同的实验结果
(3)一般情况下,转化率很低,形成的S型细菌很少,转化后形成的S型细菌可以遗传下去,快速繁殖形
成大量的S型细菌,说明S型细菌的DNA是遗传物质。
(4)(源于必修2 P43图3-2)在肺炎链(双)球菌的转化实验中,将加热杀死的S型细菌与R型细菌混
合后,注射到小鼠体内,小鼠死亡,则小鼠体内S型、R型细菌含量变化情况最可能是( )【解析】体内转化实验中,小鼠体内S型细菌、R型细菌含量的变化情况如图所示,则:
①ab段R型细菌数量减少的原因是_____。
②bc段R型细菌数量增多的原因是______________。
③后期出现的大量S型细菌是由____________________________而来的。
④上述实验中格里菲思是通过观察小鼠的生活情况来判断R型和S型细菌,除此之外,你还可以通过怎样
的方法区别R型和S型细菌?
3.T2噬菌体侵染细菌的实验
(1)“二看法”判断子代T2噬菌体标记情况
(2)实验误差分析
①35S标记的一组,为什么沉淀中出现了放射性?
用35S标记的噬菌体侵染大肠杆菌,理论上讲 : 含有35S标记的蛋白质均不能进入大肠杆菌,离心后全
存在于上清液. 实际上 : 沉淀物中也有少量放射性,原因是:
由于搅拌不充分,有少量35S的噬菌体蛋白质外壳吸附在细菌表面,随细菌离心到沉淀物中,使沉淀物
中出现少量的放射性。
②32P标记的一组,为什么上清液中出现了放射性?
A.保温时间过短,部分噬菌体的DNA还没有进入大肠杆菌细胞内,经离心后分布于上清液中,使上清液
出现放射性;
B.保温时间过长,噬菌体在大肠杆菌内增殖后释放子代噬菌体,经离心后分布于上清液,也会使上清液
出现放射性。1952年“噬菌体小组”的赫尔希和蔡斯研究了T2噬菌体的蛋白质和DNA在侵染细菌过程中的功能,搅拌
离心后的实验数据如图所示,请分析:
(1)图中被侵染的细菌的存活率基本保持在100%,本组数据的意义
是____________________________。
(2) 细 胞 外 的 32P 含 量 有 30% , 原 因 是
__________________________________。
(2020·浙江1月选考,23)某研究小组用放射性同位素32P、35S
分别标记T2噬菌体,然后将大肠杆菌和被标记的噬菌体置于培养液中培养,如图所示。一段时间后,分
别进行搅拌、离心,并检测沉淀物和上清液中的放射性。下列分析错误的是
A.甲组的上清液含极少量32P标记的噬菌体DNA,但不产生含32P的子代噬菌体
B.甲组被感染的细菌内含有32P标记的噬菌体DNA,也可产生不含32P的子代噬菌体
C.乙组的上清液含极少量35S标记的噬菌体蛋白质,也可产生含35S的子代噬菌体
D.乙组被感染的细菌内不含35S标记的噬菌体蛋白质,也不产生含35S的子代噬菌体
4.请总结:探索“遗传物质”的思路和方法,并完成填空:
(1)探究思路:探究哪种物质是遗传物质——设法将物质分开,单独看其作用 。(2018全国1卷)根据遗传物质的化学组成,可将病毒分为RNA病毒和DNA病毒病毒两种类型。有些病
毒对人类健康会造成很大危害。通常,一种新病毒出现后需要确定该病毒的类型。
假设在宿主细胞内不发生碱基之间的相互转换,请利用放射性同位素标记的方法,以体外培养的宿主细
胞等为材料,设计实验以确定一种新病毒的类型。
简要写出:
⑴ 实验思路,
⑵ 预期实验结果及结论即可。
(要求:实验包含可相互印证的甲、乙两个组)
考点二 烟草花叶病毒感染实验及遗传物质
1.少数病毒遗传物质的探索:烟草花叶病毒侵染烟草叶片的实验
烟草花叶病毒的遗传物质是RNA实验结论:RNA也是遗传物质
(2023重庆模拟)已知烟草花叶病毒(TMV)和车前草病毒(HRV)都能侵染烟草叶片,且两者都由蛋白质和RNA
组成,如图是探索HRV的遗传物质是蛋白质还是RNA的操作流程图。请据图分析下列说法错误的是( )
A.本实验运用了对照原则,无空白对照组
B.实验过程中重组病毒的后代是HRV
C.该实验只能说明RNA是HRV的遗传物质
D.若运用放射性同位素标记法,不能选择15N标记
2.生物体内的核酸种类及遗传物质1.(2023·天津·统考高考真题)下列生物实验探究中运用的原理,前后不一致的是( )
A.建立物理模型研究DNA结构- 研究减数分裂染色体变化
B.运用同位素标记法研究卡尔文循环- 研究酵母菌呼吸方式
C.运用减法原理研究遗传物质- 研究抗生素对细菌选择作用
D.孟德尔用假说演绎法验证分离定律- 摩尔根研究伴性遗传
2.(2022·海南·统考高考真题)某团队从下表①~④实验组中选择两组,模拟T2噬菌体侵染大肠杆菌实
验,验证DNA是遗传物质。结果显示:第一组实验检测到放射性物质主要分布在沉淀物中,第二组实验
检测到放射性物质主要分布在上清液中。该团队选择的第一、二组实验分别是( )
T 噬菌体 大肠杆菌
2
① 未标记 15N标记
② 32P标记 35S标记
③ 3H标记 未标记
④ 35S标记 未标记
A.①和④ B.②和③ C.②和④ D.④和③
3.(2022·湖南·高考真题)T 噬菌体侵染大肠杆菌的过程中,下列哪一项不会发生( )
2
A.新的噬菌体DNA合成
B.新的噬菌体蛋白质外壳合成
C.噬菌体在自身RNA聚合酶作用下转录出RNA
D.合成的噬菌体RNA与大肠杆菌的核糖体结合
4.(2022·浙江·高考真题)下列关于“噬菌体侵染细菌的实验”的叙述,正确的是( )
A.需用同时含有32P和35S的噬菌体侵染大肠杆菌 B.搅拌是为了使大肠杆菌内的噬菌体释放出来
C.离心是为了沉淀培养液中的大肠杆菌 D.该实验证明了大肠杆菌的遗传物质是DNA
5.(2021·全国·高考真题)在格里菲思所做的肺炎双球菌转化实验中,无毒性的R型活细菌与被加热杀
死的S型细菌混合后注射到小鼠体内,从小鼠体内分离出了有毒性的S型活细菌。某同学根据上述实验,
结合现有生物学知识所做的下列推测中,不合理的是( )
A.与R型菌相比,S型菌的毒性可能与荚膜多糖有关
B.S型菌的DNA能够进入R型菌细胞指导蛋白质的合成
C.加热杀死S型菌使其蛋白质功能丧失而DNA功能可能不受影响
D.将S型菌的DNA经DNA酶处理后与R型菌混合,可以得到S型菌
6.(2021·浙江·统考高考真题)下列关于遗传学发展史上4个经典实验的叙述,正确的是( )A.孟德尔的单因子杂交实验证明了遗传因子位于染色体上
B.摩尔根的果蝇伴性遗传实验证明了基因自由组合定律
C.T 噬菌体侵染细菌实验证明了DNA是大肠杆菌的遗传物质
2
D.肺炎双球菌离体转化实验证明了DNA是肺炎双球菌的遗传物质